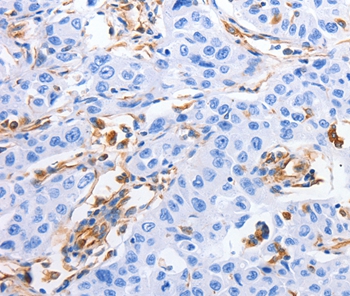

MFN1 Monoclonal Antibody
BSM-60386M
ApplicationsImmunoFluorescence, Western Blot, ImmunoCytoChemistry, ImmunoHistoChemistry, ImmunoHistoChemistry Frozen, ImmunoHistoChemistry Paraffin
Product group Antibodies
TargetMFN1
Overview
- SupplierBioss Antibodies
- Product NameMFN1 Monoclonal Antibody
- Delivery Days Customer16
- ApplicationsImmunoFluorescence, Western Blot, ImmunoCytoChemistry, ImmunoHistoChemistry, ImmunoHistoChemistry Frozen, ImmunoHistoChemistry Paraffin
- Applications SupplierWB(1:300-5000), IHC-P(1:200-400), IHC-F(1:100-500), IF(), ICC/IF(1:50-100)
- CertificationResearch Use Only
- ClonalityMonoclonal
- Clone IDG4A3
- Concentration1 mg/ml
- ConjugateUnconjugated
- Gene ID55669
- Target nameMFN1
- Target descriptionmitofusin 1
- Target synonymsfzo homolog; hfzo1; hfzo2; mitochondrial transmembrane GTPase Fzo-1; mitochondrial transmembrane GTPase FZO-2; mitofusin-1; putative transmembrane GTPase; transmembrane GTPase MFN1
- HostMouse
- IsotypeIgG2a
- Protein IDQ8IWA4
- Protein NameMitofusin-1
- Storage Instruction-20°C
- UNSPSC12352203